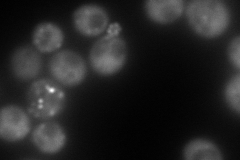
YNL138W
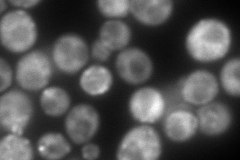
YNL138W
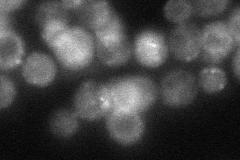
YNL138W

View description
CAP (cyclase-associated protein) subunit of adenylyl cyclase complex; N-terminus binds adenylyl cyclase and facilitates activation by RAS; C-terminus binds ADP-actin monomers, facilitating regulation of actin dynamics and cell morphogenesis
Localization:
Intensity:
Fold change:
Significance:
-
C’ GFP library in SD

punctate:cytosol45.23 -
N' NOP1pr-GFP in SD
cytosol,punctate307.618 -
N' TEF2pr-mCherry in SD
punctate,bud neck320.52 -
N' NATIVEpr-GFP in SD
punctate,bud neck53.375 -
N' TEF2pr-VC and Cyto-VN in SD

#N/A0 -
C’ GFP library in SD+DTT

punctate.cytosol73.051.61Yes -
C’ GFP library in SD+H2O2

punctate.cytosol52.731.16No -
C’ GFP library in Starvation Media

punctate,cytosol72.761.6Yes -
C’ GFP library on the background of Pup2-DaMP

punctate:cytosol -
C’ GFP library on the background of CCT mutant

punctate:cytosol58.05421.28342No
